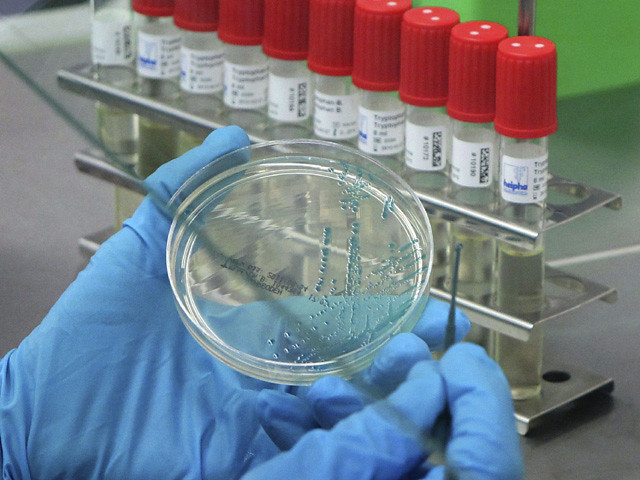

Desde el principio de los tiempos, el ser humano ha estado en continuo contacto con la naturaleza. Esto ha hecho que sean muchas las plantas consideradas como medicinales. Una de ellas es la equinácea.
Aunque quizá este nombre no sea tan conocido como otros, ya que existe una gran variedad de plantas y flores recomendables para la salud, lo cierto es que cuenta con una gran cantidad de beneficios que es imprescindible conocer.
¿Lo sabías? Descubre qué es la equinácea y por qué en tan vital para tu salud.
4La equinácea reduce las infecciones y puede prevenir el cáncer
Asimismo, la equinácea también se utiliza para tratar infecciones como la malaria, el herpes genital, la sífilis, la infección vaginal por hongos o las infecciones de las encías, entre muchas otras. También se ha relacionado a esta planta con la prevención del cáncer, ya que estimula el sistema inmunitario para eliminar las células cancerosas. A pesar de que no se considera como un antioxidante, ayuda a eliminar los radicales libres estimulando células del sistema inmune como las T, algo que ayuda a prevenir el desarrollo del cáncer.

